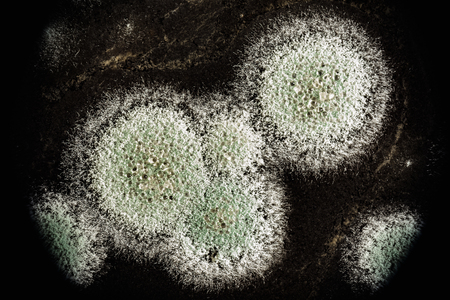
development of green mold on an black organic basis, macro abstract backgroundの写真素材

写真素材 - development of green mold on an black organic basis, macro abstract background
作品情報
development of green mold on an black organic basis, macro abstract background
- ID:95667012
- 作品種別:写真
- 作者名:Aliaksei Marozau
キーワード
- abstract
- analysis
- antibiotics
- bacillus
- biology
- didactic
- dirty
- disease
- environmental
- experiment
- food
- fungal
- fungi
- fungus
- germs
- growth
- hazard
- health
- laboratory
- life
- macro
- medical
- medicine
- microbe
- microbiology
- mildew
- mold
- moldy
- mould
- mycelia
- natural
- organic
- organism
- petri
- plant
- proliferation
- replication
- research
- rotten
- safety
- sanitation
- science
- sickness
- spoiled
- spore
- spread
- substance
- subtilis
- toxic
- unhealthy
類似作品
Old concrete ab...
A stream of fin...
Close up of bla...
Water on the ro...
Abandoned build...
A close up of a...
Winter sowing. ...
Rocks by the se...
Green fern grow...
Closeup of blue...
Dark, wet, text...
Concrete textur...
abstract backgr...
Microscopic Rot...
black mold on t...
Green moss on c...
Nori seaweed is...
This close-up i...
Oil bubbles. Gl...
Ink mix backgro...
Old wall paint ...
Concrete textur...
Green sprouts s...
Abstract paint ...
the image of mo...
Moss on the roc...
Grunge backgrou...
A captivating c...
beautiful green...
Macro shot of v...
Moldy walls ove...
Closeup on volc...
Two stone plant...
Mold and fungus...
Green sprouts s...
Close up of bla...
A collection of...
Close-up Of A P...
corner green mo...
A dark, texture...
Old concrete ab...
development of ...
An image of a g...
Lush green terr...
Colonies of Pen...
A gloved hand s...
Green moss and ...